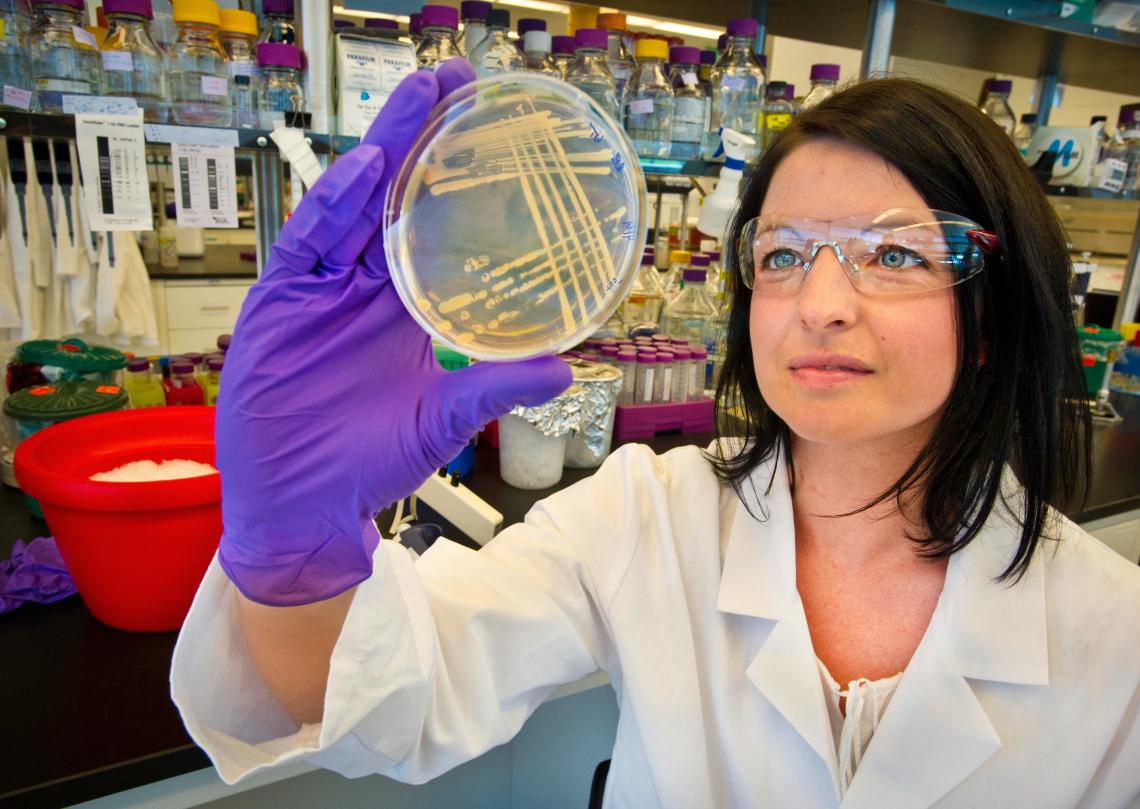
female scientist looking at a petri dish

The April 2021 Xchange highlights some of the contributions that have been published on ChemEd X over the past month. We hope you will take a moment to check in and see what you may have missed. Special thanks to first time ChemEd X authors, Jason Bradshaw (Representation in STEM Education) and Rajasree Swaminathan (The Magical Periodic Table and The Element Girls Series). If you would like to contribute content, begin with the contribute page.
Representation in STEM EducationThe diversification of STEM and STEM education is not going to happen overnight, but we all move it forward with what we do today. It is incumbent to us as educators to acknowledge and celebrate the different identities in our classrooms.
|
||
Energizer Lab with Virtual OptionsIn this lab, students connect the workings of an electrochemical cell in the lab with the symbolic equations used in electrochemistry and manipulate a model representing the particulate level of what is happening during the electrochemical process. Although this lab was previously highlighted on ChemEd X, Melissa Hemling has provided virtual options! |
||
Effect of Temperature on Chemical Equilibrium using Copper ComplexesTom Kuntzleman describes a simple way to generate blue, green, orange, and yellow copper complexes, and to use these complexes to introduce students to the effect of temperature on chemical equilibria. The protcol avoids the use of caustic agents, allowing the experiments to be conducted by students as a laboratory-based investigation. |
||
Some of My Favorite Things for VSEPRMelissa Hemling shares her favorite manipulatives along with cheap at-home alternatives to help students visualize VSEPR. Also check out Melissa's blog post, Dust Off Your Molecule Kits!, and find new lessons to use them in! |
||
Developing a Model for Enthalpy of Solution—Reframing the ApproachBen Meacham decided to alter his approach to teaching about enthalpy and focus on getting students to first develop the mathematical model for enthalpy of solution so they could eventually apply it to make predictions for different solutes being dissolved. In this blog post he shares the process he used with his class. |
||
The Carbon Dioxide Spiral StaircaseThe demonstration where CO2 is generated and used to snuff out a candle in an aquarium or other container is well known. This article describes a dramatic variation on these demonstrations that allows for discussion of such topics as the ideal gas law, densities of different gases, gas density changes with temperature, miscibility, and viscosity. The device described is easily and inexpensively produced and stored. The demonstration is large scale and works well for classrooms and community outreach events. |
||
3DL4US Podcast3DL4US: A New podcast explores the extension of three-dimensional learning to higher education. Many episodes are relevant for K-12 educators as well. |
||
Demonstration: Colorful Sugar Density ColumnAssembling a large graduated cylinder with colored sugar solutions of various densities is described. By filling the cylinder in the reverse order from bottom up, very little mixing occurs resulting in an attractive classroom demonstration to illustrate density. Students also have to opportunity to practice density and dilution calculations. |
||
Standards Based Grading, Final Exams and Thinking Outside the BoxIt has been a challenging year. The challenge gave rise to a unique way to provide exams in a multitude of platforms. Check it out and do not be afraid to share some ideas of your own! |
||
Perfecting Mole ConversionsIf a student “gets the wrong answer” while performing mole conversions, it can be difficult (for both student and the teacher) to discern where an error was made. Near the beginning of learning these conversions, students can become overly confident, plugging numbers in without thinking about whether they are sensical. Katy Dornbos uses this card set that slows students down to think about the order and purpose of each of the steps in mole conversions. Katy also published another activity this past month, Bringing Chemistry to Life. |
||
Photochromic glue and spring decorationsThe many colors of springtime can be illustrated with photochromic pigments in commercial products. These products include UV beads, and more recently, photochromic glue. The glue can be used as a photochromic paint for paper or even eggs. The resulting colorful, decorative objects can be used to illustrate chemical discussions of aspects of photochemistry. |
||
How much carbon dioxide is produced from a gallon of gasoline?This classroom activity challenges students to figure out the volume of gaseous carbon dioxide emitted from the combustion of 1 gallon of gasoline fuel. |
||
The Magical Periodic Table and The Element Girls SeriesRajasree Swaminathan has developed a series of books that combines story-telling and visual representation of the elements as human characters. Along with hands-on activities, these books have created enthusiasm in her chemistry classes. |
Atom and her dog, Electron |
|
Skype with a Scientist LiveMany in-person events at school have not been able to happen due to COVID restrictions. One activity that Stephanie O'Brien's science honor society students have enjoyed greatly is the Skype with a Scientist Live sessions. Students register in advance and then have the opportunity to be face to face with a scientist. |
||
JCE 98.04 April 2021 Issue HighlightsThe April 2021 issue of the Journal of Chemical Education is now available online to subscribers. Topics featured in this issue include: environmental chemistry; curriculum innovation; redesigning courses; representation in chemistry textbooks; public understanding of chemistry; teaching with models; visual and aural demonstrations; teaching chemistry with inks and pigments; examining the chemistry of beer; synthesis in the laboratory; improving student understanding of analysis; instrumentation; chemistry education research; from the archives: resources for celebrating Earth Week 2021. |
||
We hope you enjoy the content mentioned here and other content at ChemEd X. If you find ChemEd X content useful, please consider purchasing a subscription to help support ChemEd X using our online store. In addition to supporting the free content we make available, you will also get access to our complete video collection and other titles to help in teaching and learning chemistry. If you would like to contribute content, begin with the contribute page. For other questions or comments, please use our contact form.